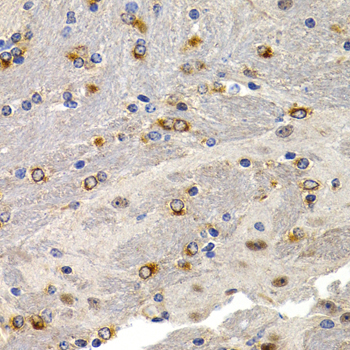

For quotations, please use our online quotation form, and you may also contact us by
service@kendallscientific.com
+1-888.733.6849 (Toll-free)
+1-617.299.7367 (Int’l))
+1-888.733.6849
Our customer service representatives are available 24 hours, Monday through Friday to assist you.| Reactivity | Human Mouse Rat |
| Tested applications | WB IHC |
| Recommended Dilution | WB 1:500 - 1:1000 IHC 1:50 - 1:200 |
| Calculated MW | 9kDa |
| Observed MW | Refer to Figures |
| Immunogen | Recombinant protein of human TFF1 |
| Storage Buffer | Store at -20℃. Avoid freeze / thaw cycles. Buffer: PBS with 0.02% sodium azide, 50% glycerol, pH7.3. |
| Synonym | pS2; BCEI; HPS2; HP1.A; pNR-2; D21S21; |

Western blot analysis of extracts of BT474 cells, using TFF1 antibody.

Western blot analysis of extracts of various cells, using TFF1 antibody.

Immunohistochemistry of paraffin-embedded human breast cancer using TFF1 antibody at dilution of 1:200 (400x lens).

Immunohistochemistry of paraffin-embedded 人human liver cancer using TFF1 antibody at dilution of 1:200 (400x lens).

Immunohistochemistry of paraffin-embedded rat lung using TFF1 antibody at dilution of 1:200 (400x lens).
Immunohistochemistry of paraffin-embedded rat kidney using TFF1 antibody at dilution of 1:200 (400x lens).

Immunohistochemistry of paraffin-embedded mouse brain using TFF1 antibody at dilution of 1:200 (400x lens).

Immunohistochemistry of paraffin-embedded human colon cancer using TFF1 antibody at dilution of 1:200 (400x lens).

Immunohistochemistry of paraffin-embedded human colon cancer using TFF1 antibody at dilution of 1:200 (400x lens).

Immunohistochemistry of paraffin-embedded human normal stomach using TFF1 antibody at dilution of 1:200 (400x lens).
Members of the trefoil family are characterized by having at least one copy of the trefoil motif, a 40-amino acid domain that contains three conserved disulfides. They are stable secretory proteins expressed in gastrointestinal mucosa. Their functions are not defined, but they may protect the mucosa from insults, stabilize the mucus layer, and affect healing of the epithelium. This gene, which is expressed in the gastric mucosa, has also been studied because of its expression in human tumors. This gene and two other related trefoil family member genes are found in a cluster on chromosome 21.
N/A